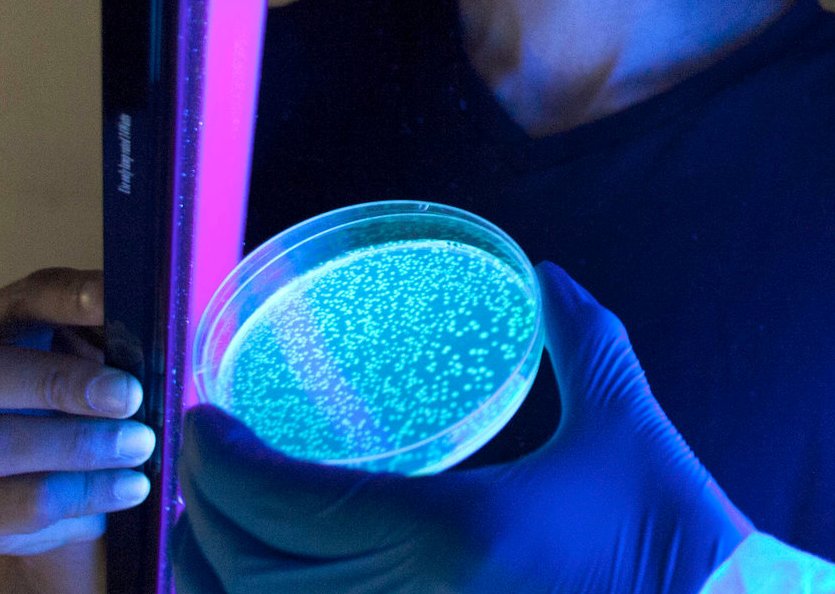
El eterno femenino de una imaginativa pintora

El remedio está plasmado en el Bald's Leechbook, un libro de medicina anglosajona del siglo IX
Un remedio natural contra infecciones oculares, descrito en un manuscrito que data de hace un siglo, podría ser la clave para acabar con las superbacterias resistentes a los antibióticos, estiman especialistas británicos.
Los científicos recrearon un receta medieval utilizando cebolla, ajo y una parte del estómago de una vaca, y encontraron que este remedio "aniquila casi por completo" a la bacteria Staphylococcus aureus resistente a la meticilina (SARM).
El remedio está plasmado en el Bald's Leechbook, un libro de medicina anglosajona del siglo IX que contiene varios tratamientos curativos, el cual se encuentra bajo resguardo de la Biblioteca Británica.
La experta en anglosajón de la Universidad de Nottingham, doctora Chritina Lee, tradujo la receta de un "bálsamo de ojo" , que incluye ajo, cebolla, vino y hiel de vaca, y especialistas en microbiología lo elaboraron para realizar pruebas con amplios cultivos de bacterias.
Los expertos, de la misma universidad, encontraron que este remedio natural prácticamente "mata" al SARM (en un 90%) , el cual se volvió resistente a la penicilina y más tarde a la meticilina.
En el efecto de la receta intervienen todos los ingredientes, "no solo uno", aseguran los especialistas, que presentarán sus conclusiones en la próxima conferencia nacional de microbiología.
El Bald's Leechbook es uno de los primeros ejemplos de lo que podría llamarse vagamente un libro de texto médico, pues contiene lecciones importantes para combatir enfermedades microbianas, precisa la cadena británica de noticias BBC.
Al parecer, los médicos anglosajones en realidad habrían practicado algo muy parecido al método científico moderno, con su énfasis en la observación y la experimentación, añade.
La doctora Lee afirma que hay muchos libros medievales similares con tratamientos naturales contra infecciones bacterianas, lo cual sugiere que las personas de aquella época estaban realizando estudios detallados desde mucho antes de que se descubrieran las bacterias.
SALUDEl Universal/GDA